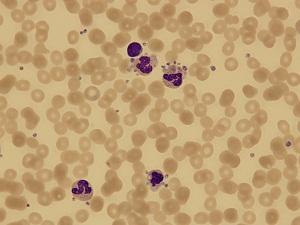
血小板减少症+-+搜搜百科

原发性血小板增多症诊断与治疗中国专家共识(2016年版)-血液科指南-MedSci.cn
400x400 - 41KB - JPEG

慢性免疫性血小板减少症新药公布3期临床结果
402x272 - 174KB - PNG

血小板减少的病因机制_求医网
277x266 - 34KB - JPEG

血小板数值减少用生成素,效果怎么样?-疾病防治-就爱阅读网
523x572 - 51KB - JPEG

原发性免疫性血小板减少性紫癜2期临床试验结果表明rozrolimupab安全性和疗效俱佳 - 医药新闻 - 行业动态 - 有机化学网
403x303 - 34KB - JPEG
血小板减少症+-+搜搜百科
300x225 - 10KB - JPEG

血小板减少的临床症状 如何预防病情的呢_济南血液病医院【官方网站】
326x209 - 10KB - JPEG

12年都反反复复伴有血小板减少症_体检_奇飞知识网
340x220 - 23KB - JPEG

沈志祥教授:原发免疫性血小板减少症(ITP)诊疗中国专家共识解读-MedSci.cn
493x335 - 51KB - JPEG

儿童免疫性血小板减少症怎么治疗,吃什么好 - 增强免疫力专题 - 回头鱼保健品商城 www.huitouyu.com
670x420 - 56KB - JPEG

病理解析:免疫性血小板减少是怎么发生的?身体究竟发生了什么? _【今日爆点】
500x375 - 24KB - JPEG

免疫性血小板减少症 - 搜狗百科
268x201 - 9KB - JPEG

细胞计数是确定血小板减少症及其严重性的关键性检查
300x228 - 20KB - JPEG

原发免疫性血小板减少症出血评分系统
800x316 - 66KB - PNG

免疫性血小板减少症_互动百科
300x217 - 23KB - JPEG
问题分析:血小板低是血液病的一种,也是非常严重的一种,给患者的生命造成极大的威胁,此病的发病趋势不容许人们忽视,在生活中有很多人对血小板减少的危害并不了解,导致血小板低出现后没有引起重视,没有及时检查和治疗,使病情加重。 意见建议:找对一家正规中医院是治愈的一半,采用中医疗法进行全面调理,从病根彻底解决问题
病情分析: 免疫性血小板减少症者,这是属于比较严重的自身免疫性的疾病。 指导意见: 是慢性的,目前没有办法可以治愈,需要使用激素或者是免疫抑制剂治疗的。会有反复发作的可能性。
你有特发性血小板减少性紫癜,在治疗上,主要是抗组胺,配合芦丁、维生素、激素等治疗,治疗一段时间后,疗效差了,还得加免疫抑制剂等,若仍不能控制,只能切脾。平时均衡营养
免疫性血小板减少症 高高兴兴140|2014-07-23 |举报 共享文档 共享文档是百度文库用户免费上传的可与其他用户免费共享的文档,具体共享方式由上传人自由设定。了解文档类
到了周一复查血小板又降到了53,一天降了两个点,瞬间整个人都不好了,又是检查等结果,挂了个专家号,医生说你这个是免疫性血小板减少症,刚开始是高兴的,因为一直担心怕是白
简介:除非血小板数降至30000/μl以下,一般不予使用,因药物可进一步抑制免疫功能.大多数患者使用抗病毒药物治疗血小
原发免疫性血小板减少症(primary immune thrombocytopenia ITP)是以出血及外周血血小板减少,骨髓巨核细胞数正常或增多并伴有成熟障碍为主要
和白血病相比,大众对原发免疫性血小板减少症(ITP)的了解相对较少。夏季上火流鼻血或牙龈出血,轻微磕碰后皮肤出现紫斑,这是生活中常见的出血小
原发免疫性血小板减少症(immune thrombocytopenia,ITP),既往亦称特发性血小板减少性紫癜(idiopathic thrombocytopenia purpura,ITP ),是一种复杂的多种机制共同参与的获得性